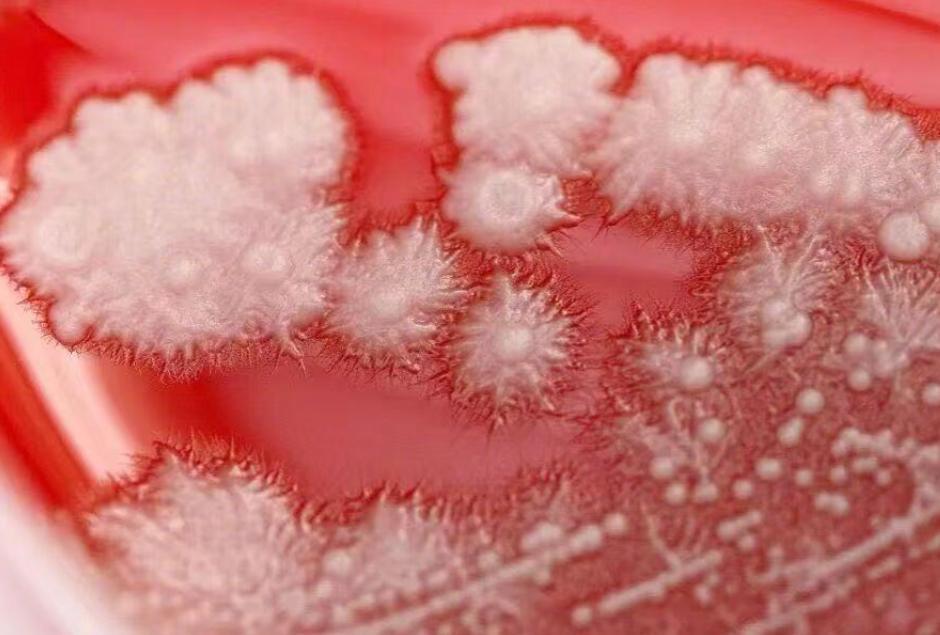

張男的咽喉布滿白色斑點,宛如雪花。(圖/翻攝新浪微博)

浙江省寧波市一名36歲男子,日前因喉嚨痛自行買藥服用抗生素治療,不料症狀非但未改善,反而愈發嚴重,經醫院檢查發現,其咽喉內壁覆蓋一層白茫茫的「雪花」,確診為真菌性咽喉炎。
以為只是「上火」或「發炎」
《都市快報》報道,這名張姓男子從事銷售工作,平日工作繁忙、經常熬夜與出差,約一個月前他出現喉嚨痛,以為只是「上火」或「發炎」,於是自行購買抗生素服用,希望「消消炎」。豈料症狀不僅未見好轉,反而出現吞嚥不適、喉嚨灼熱等情況。

醫生使用喉鏡檢查後赫然發現,張男的咽喉後壁布滿白色斑點,「就像覆上一層雪花」,進一步化驗顯示,病原體為白色念珠菌,並非一般細菌感染。醫生表示:「抗生素雖能殺死致病菌,但它不分青紅皂白,會把口腔和咽喉內的『好菌』與『壞菌』一併消滅,這就給白色念珠菌提供了生長空間。」
長期熬夜壓力大促病
醫生指出,長期熬夜、壓力大等生活習慣,也會導致免疫力下降:「在多重因素作用下,真菌感染便趁虛而入,最終引發真菌性咽喉炎。」醫生提醒民眾,抗生素主要針對細菌感染,對病毒性或真菌性疾病無效:「若自行用藥不當,反而可能導致菌群失衡,讓病情更複雜。」

他建議,若出現喉嚨痛、發熱、吞嚥困難等症狀,應及時前往醫院就診,切勿盲目服用抗生素。
文章授權轉載自《中天新聞網》,按此查看原始文章



















